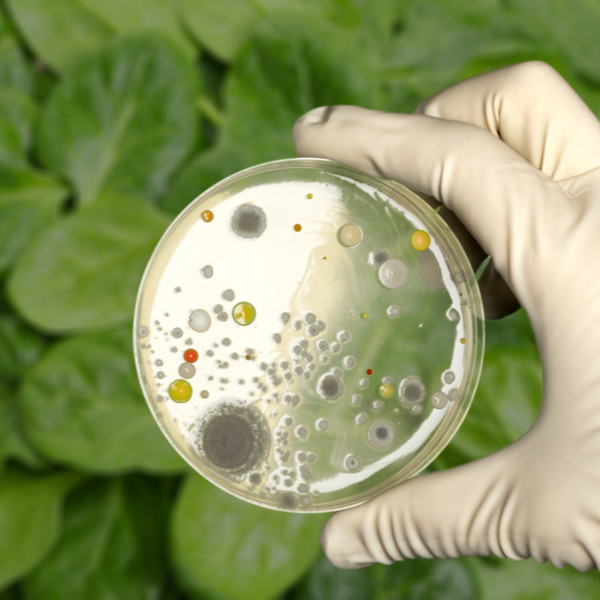

A world class multihead weigher, combined with state of the art technology
This revolutionary solution delivers excellent performance at an affordable price
High speeds, accuracy and unrivalled price performance ratio
Reduce waste and minimise risk of sealing failure
Designed for high speeds and accuracy while increasing productivity
Outstanding performance and excellent reliability in competitive conditions
Improve quality control and supermarket compliance with an added metal detector
Inspect and detect unwanted contaminants in your products
Ideal for fixed weight packaging where items are irregular in size and shape, are sticky and where an element of manual control needs to be retained
An accurate and robust weighing solution ideal for weighing small batches of products and carrying out final checks
Fully integratable indicator displays to help collate and control your data from multiples sources
Yamato Data Recordings puts live production information at your fingertips. Monitor weigh and yield information from multihead weighers and checkweighers. View audit records from metal detectors and performance data from the whole line to reduce costs and ensure compliance consistently.